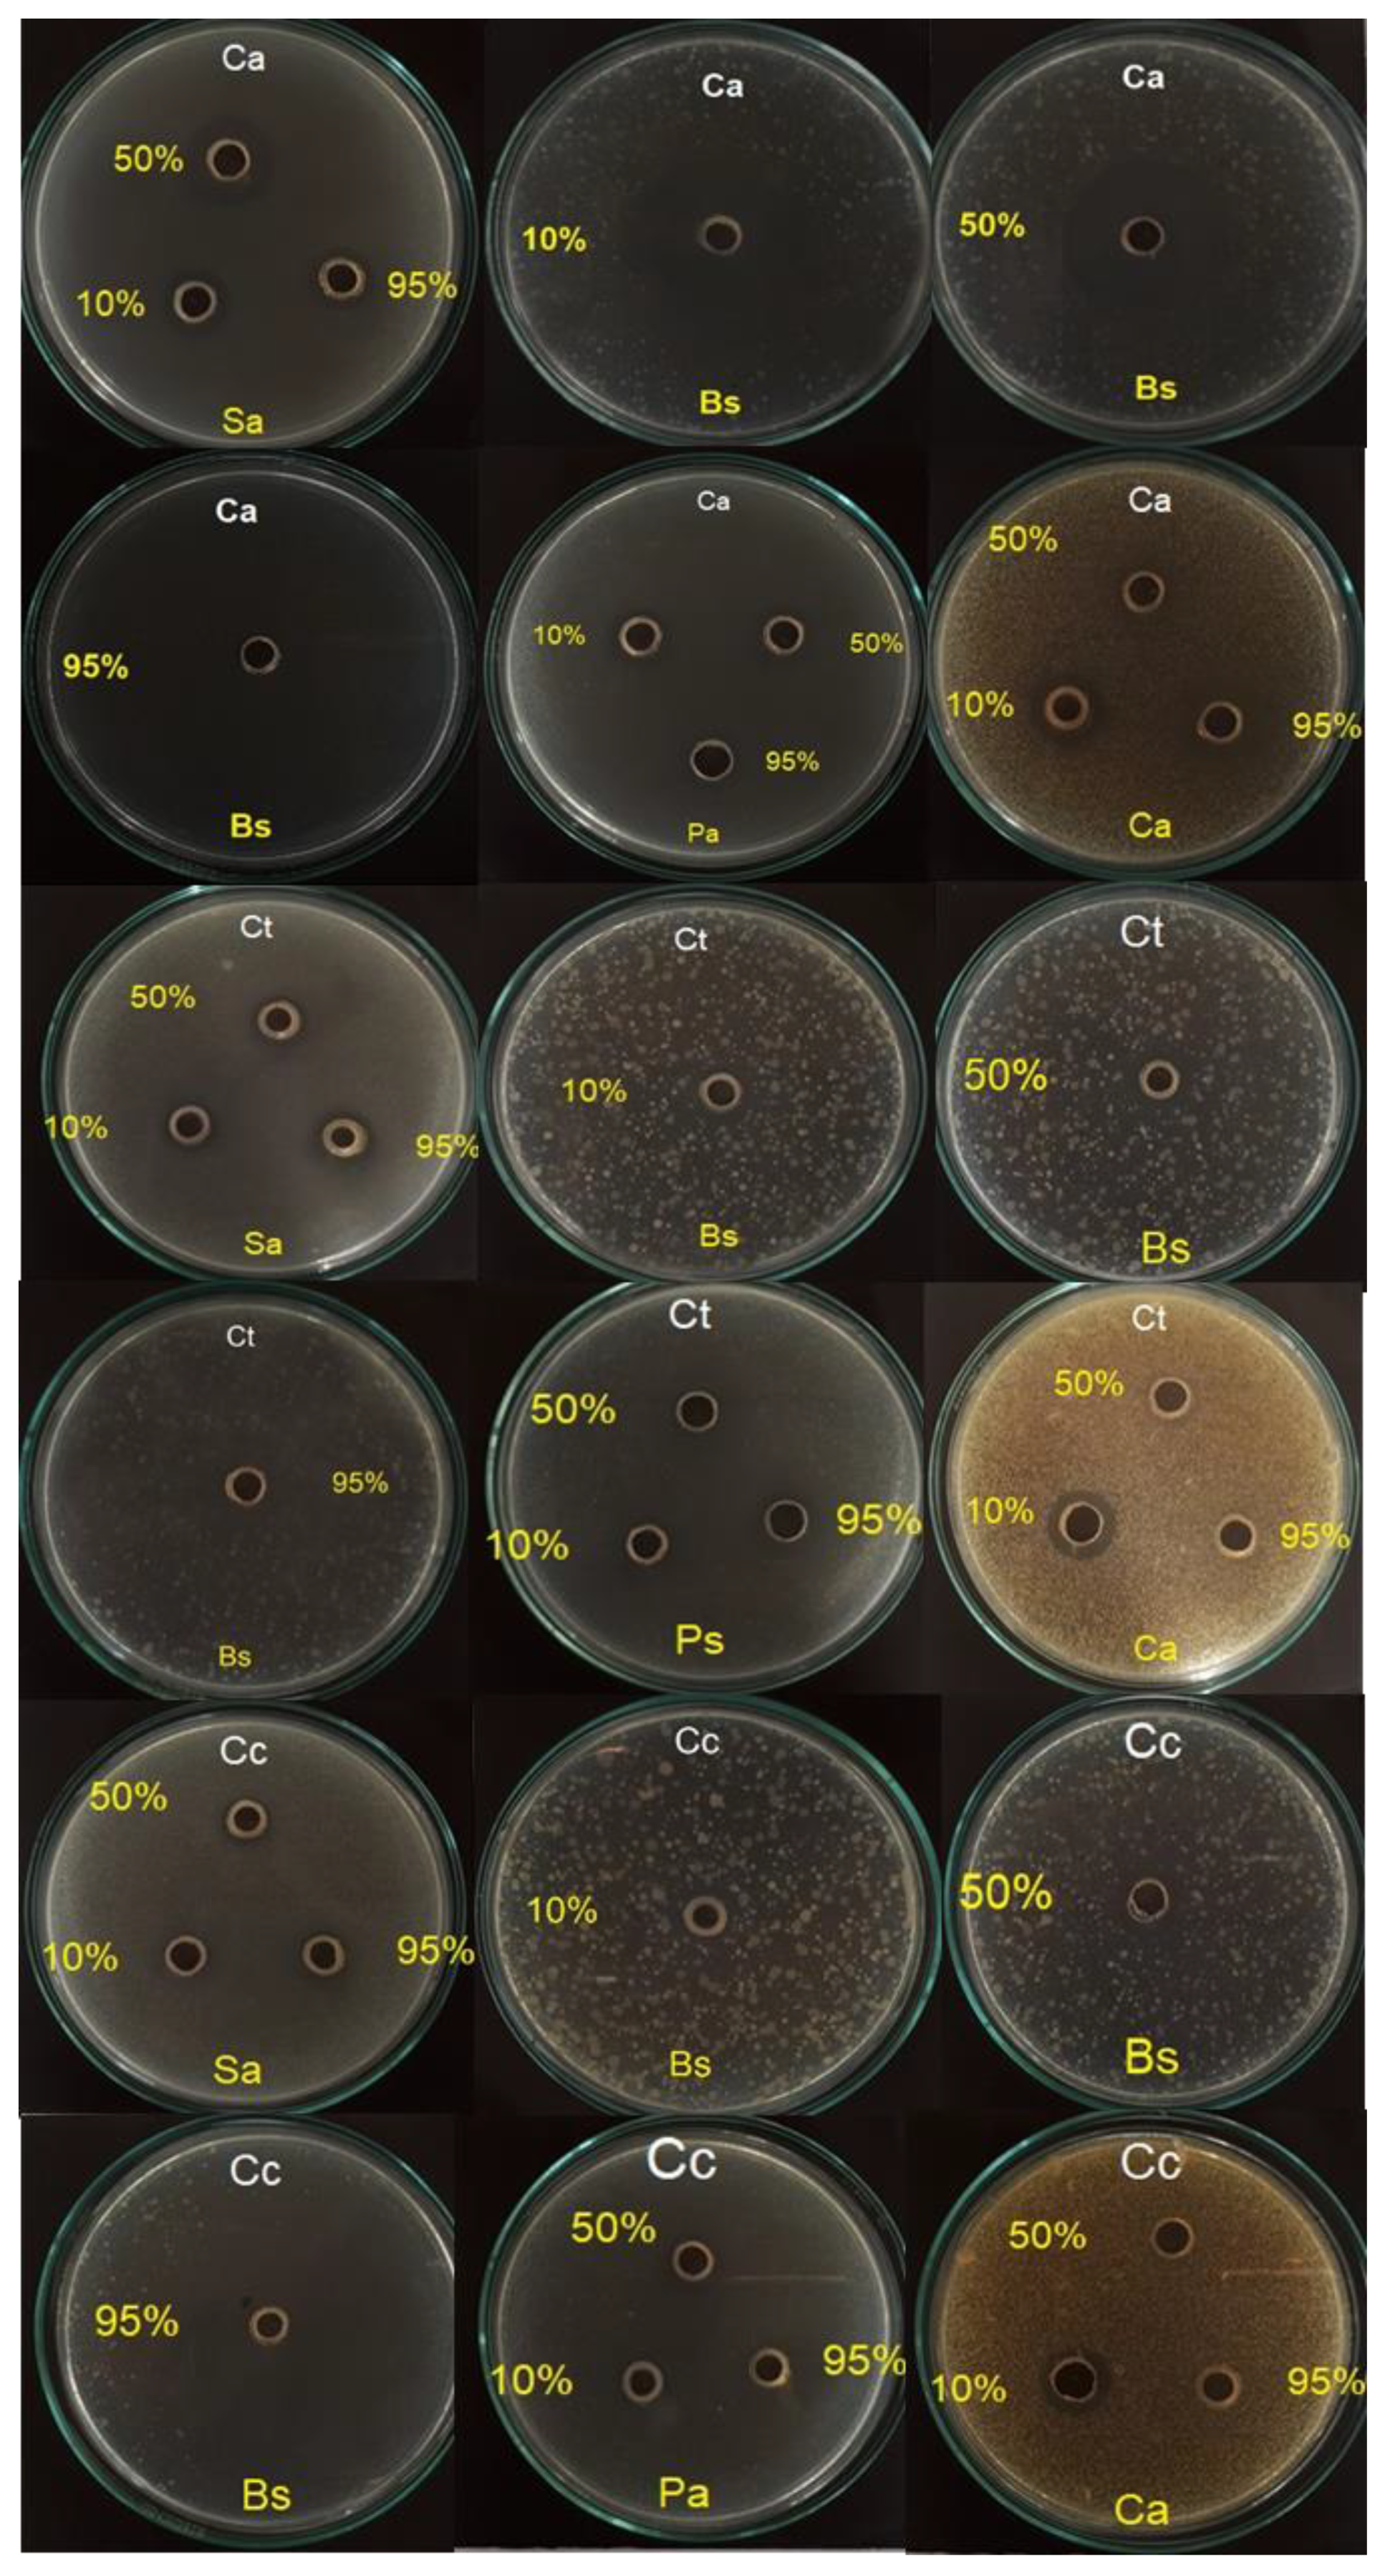
Antibiotics 10 01387 g002 Antibiotics 10 01387 g002

Chemical Profile of the Volatile Constituents and Antimicrobial Activity of the Essential Oils from Croton adipatus, Croton thurifer, and Croton collinus
Abstract
1. Introduction
2. Results and Discussion
2.1. Phytochemical Screening of the Volatile Components of the Essential Oils from Croton Species
2.2. Antimicrobial Activity of the Essential Oils of Croton Species
2.2.1. Agar Diffusion Method
2.2.2. Colorimetric Microdilution Method
3. Materials and Methods
3.1. Collection of the Plant Material
3.2. Extraction of Essential Oils of Croton Species
3.3. Chemical Analysis by Gas Chromatography Coupled to Mass Spectrometry (GC-MS) of the Essential Oils of Croton Species
3.4. Evaluation of the Antimicrobial Activity of the Essential Oils of Croton Species
3.4.1. Agar Diffusion Method
3.4.2. Colorimetric Microdilution Method and Determination of MIC
3.5. Statistical Treatment
4. Conclusions
Supplementary Materials
Author Contributions
Funding
Institutional Review Board Statement
Informed Consent Statement
Data Availability Statement
Acknowledgments
Conflicts of Interest
References
- Beraud, G. Shortages Without Frontiers: Antimicrobial Drug and Vaccine Shortages Impact Far Beyond the Individual! Front. Med. 2021, 8, 46. [Google Scholar] [CrossRef]
- Abubakar, A.R.; Haque, M. Preparation of medicinal plants: Basic extraction and fractionation procedures for experimental purposes. J. Pharm. Bioallied Sci. 2020, 12, 1–10. [Google Scholar] [CrossRef]
- Chouhan, S.; Sharma, K.; Guleria, S. Antimicrobial Activity of Some Essential Oils—Present Status and Future Perspectives. Medicines 2017, 4, 58. [Google Scholar] [CrossRef]
- Raut, J.S.; Karuppayil, S.M. A status review on the medicinal properties of essential oils. Ind. Crop. Prod. 2014, 62, 250–264. [Google Scholar] [CrossRef]
- Zinngrebe, Y. Learning from local knowledge in Peru—Ideas for more effective biodiversity conservation. J. Nat. Conserv. 2016, 32, 10–21. [Google Scholar] [CrossRef]
- Leon, B.; Riina, R.; Berry, P. Euphorbiaceae endémicas del Perú. Rev. Peru. Biol. 2013, 13, 295s–301s. [Google Scholar] [CrossRef]
- Berry, P.E.; Hipp, A.L.; Wurdack, K.J.; van Ee, B.; Riina, R. Molecular phylogenetics of the giant genus Croton and tribe Crotoneae (Euphorbiaceae sensu stricto) using ITS and TRNL-TRNF DNA sequence data. Am. J. Bot. 2005, 92, 1520–1534. [Google Scholar] [CrossRef] [PubMed]
- Barrera, C.A.C.; Gómez, D.C.; Castiblanco, F.A. Medicinal Importance of Croton Genus (Euphorbiaceae). Rev. Cuba. Plantas Med. 2016, 21, 234–247. [Google Scholar]
- Xu, W.-H.; Liu, W.-Y.; Liang, Q. Chemical Constituents from Croton Species and Their Biological Activities. Molecules 2018, 23, 2333. [Google Scholar] [CrossRef]
- Salatino, A.; Salatino, M.L.F.; Negri, G. Traditional uses, chemistry and pharmacology of Croton species (Euphorbiaceae). J. Braz. Chem. Soc. 2007, 18, 11–33. [Google Scholar] [CrossRef]
- De Araújo, A.C.J.; Freitas, P.R.; Barbosa, C.R.D.S.; Muniz, D.F.; Rocha, J.E.; Neto, J.B.D.A.; Da Silva, M.M.C.; Moura, T.F.; Pereira, R.L.S.; Ribeiro-Filho, J.; et al. Essential Oil of Croton ceanothifolius Baill. Potentiates the Effect of Antibiotics against Multiresistant Bacteria. Antibiotics 2020, 9, 27. [Google Scholar] [CrossRef]
- Filho, J.M.T.D.A.; Araújo, L.D.C.; Oliveira, A.P.; Guimarães, A.L.; Pacheco, A.G.; Silva, F.; Cavalcanti, L.S.; Lucchese, A.; Almeida, J.R.D.S.; Araujo, E.C.D.C. Chemical composition and antibacterial activity of essential oil from leaves of Croton heliotropiifolius in different seasons of the year. Rev. Bras. Farm. 2017, 27, 440–444. [Google Scholar] [CrossRef]
- de Araújo, L.G.; Veras, G.; Alves, J.V.D.O.; de Veras, B.O.; da Silva, M.V.; Rodrigues, J.F.B.; Fook, M.V.L.; Amoah, S.K.S.; Torres, M.C.D.M. Chemodiversity and Antibacterial Activity of the Essential Oil of Leaves of Croton argyrophyllus. Chem. Biodivers. 2020, 17, e2000575. [Google Scholar] [CrossRef]
- Morais, S.M.; Cavalcanti, E.S.; Bertini, L.M.; Oliveira, C.L.; Rodrigues, J.R.; Cardoso, J.H. Larvicidal Activity of Essential Oils from Brazilian Croton Species against Aedes aegypti L. J. Am. Mosq. Control Assoc. 2006, 22, 161–164. [Google Scholar] [CrossRef]
- Dória, G.; Silva, W.J.; Carvalho, G.A.; Alves, P.; Cavalcanti, S.C.H. A study of the larvicidal activity of two Crotonspecies from northeastern Brazil against Aedes aegypti. Pharm. Biol. 2010, 48, 615–620. [Google Scholar] [CrossRef] [PubMed]
- Ruphin, F.P.; Baholy, R.; Sylver, S.; Oscar, R.A.Y.; Mahamoud, A.; Raymond, F.F.; Marcelin, S.; Rakotoniriana, H.J.; Amelie, R. GC-FID and GC/MS Analyses and Antimicrobial Activity of Croton Greveanus, C. Borarium and C. Geayi (Euphorbiaceae) Essential Oils from Madagascar. J. Pharmacogn. Phytochem. 2016, 5, 188–197. [Google Scholar]
- Ogundajo, A.L.; Ogunwande, I.A.; Gbadamosi, H.G.; Giwa, R.; Flamini, G. Chemical Composition of the Leaf Essential Oils of Croton zambesicus Müll.-Arg. Grown in Lagos, South-West Nigeria. Eur. J. Med. Plants 2014, 4, 1524–1533. [Google Scholar] [CrossRef]
- Azevedo, M.M.B.; Chaves, F.C.M.; Almeida, C.A.; Bizzo, H.R.; Duarte, R.S.; Campos-Takaki, G.M.; Alviano, C.S.; Alviano, D.S. Antioxidant and Antimicrobial Activities of 7-Hydroxy-calamenene-Rich Essential Oils from Croton cajucara Benth. Molecules 2013, 18, 1128–1137. [Google Scholar] [CrossRef]
- Moreno, P.R.H.; Lima, M.E.L.; Caruzo, M.B.R.; Carneiro-Torres, D.; Cordeiro, I.; Young, M.C.M. Chemical Composition and Antimicrobial Activity of the Essential Oil from Croton heterocalyx Baill. (Euphorbiaceae s.s.) Leaves. J. Essent. Oil Res. 2009, 21, 190–192. [Google Scholar] [CrossRef]
- Peixoto, R.N.S.; Guilhon, G.M.S.P.; Zoghbi, M.D.G.B.; Araújo, I.S.; Uetanabaro, A.P.T.; Santos, L.S.; Brasil, D.D.S.B. Volatiles, A Glutarimide Alkaloid and Antimicrobial Effects of Croton pullei (Euphorbiaceae). Molecules 2013, 18, 3195–3205. [Google Scholar] [CrossRef]
- de Almeida, T.S.; da Rocha, J.B.T.; Rodrigues, F.F.G.; Campos, A.R.; da Costa, J.G.M. Chemical composition, antibacterial and antibiotic modulatory effect of Croton campestris essential oils. Ind. Crop. Prod. 2013, 44, 630–633. [Google Scholar] [CrossRef]
- Melo, G.F.D.A.; Da Costa, A.C.V.; Garino, F.; Medeiros, R.S.; Madruga, M.S.; Neto, V.Q. The sensitivity of bacterial foodborne pathogens to Croton blanchetianus Baill essential oil. Braz. J. Microbiol. 2013, 44, 1189–1194. [Google Scholar] [CrossRef] [PubMed][Green Version]
- Athikomkulchai, S.; Tadtong, S.; Ruangrungsi, N.; Hongratanaworakit, T. Chemical Composition of the Essential Oil from Croton Oblongifolius and its Antibacterial Activity Against Propionibacterium Acnes. Nat. Prod. Commun. 2015, 10, 1459–1460. [Google Scholar] [CrossRef] [PubMed]
- De Heluani, C.S.; De Lampasona, M.P.; Vega, M.I.; Catalan, C.A. Antimicrobial Activity and Chemical Composition of the Leaf and Root Oils fromCroton hieronymiGriseb. J. Essent. Oil Res. 2005, 17, 351–353. [Google Scholar] [CrossRef]
- Yang, L.; Wen, K.-S.; Ruan, X.; Zhao, Y.-X.; Wei, F.; Wang, Q. Response of Plant Secondary Metabolites to Environmental Factors. Molecules 2018, 23, 762. [Google Scholar] [CrossRef]
- De, I.; Neves, A.; da Camara, C.A.G. Volatile Constituents of Two Croton Species from Caatinga Biome of Pernambuco-Brasil. Nat. Prod. 2012, 6, 161–165. [Google Scholar]
- Dai, D.N.; Huong, L.T.; Thang, T.D.; Ogunwande, I.A. Chemical Constituents of Essential Oils of the Leaves of Three Species of Croton from Vietnam. Chem. Nat. Compd. 2014, 50, 155–157. [Google Scholar] [CrossRef]
- Turiel, N.A.; Ribeiro, A.F.; Carvalho, E.; Domingos, V.D.; Lucas, F.C.A.; Carreira, L.M.M.; Andrade, E.H.D.A.; Maia, J.G.S. Essential Oils Composition of Croton Species from the Amazon. Nat. Prod. Commun. 2013, 8, 1471–1472. [Google Scholar] [CrossRef]
- Radulovic, N.; Mananjarasoa, E.; Harinantenaina, L.; Yoshinori, A. Essential oil composition of four Croton species from Madagascar and their chemotaxonomy. Biochem. Syst. Ecol. 2006, 34, 648–653. [Google Scholar] [CrossRef]
- Santos, G.K.; Dutra, K.A.; Lira, C.S.; Lima, B.N.; Napoleão, T.H.; Paiva, P.M.; Maranhão, C.A.; Brandão, S.S.; Navarro, D.M. Effects of Croton rhamnifolioides essential oil on Aedes aegypti oviposition, larval toxicity and trypsin activity. Molecules 2014, 19, 16573–16587. [Google Scholar] [CrossRef]
- Rojas, J.; Buitrago, A.; Rojas, L.B.; Cárdenas, J.; Carmona, J. Chemical Composition of the Essential Oil of Croton huberi Steyerm. (Euphorbiaceae) Collected from Tachira-Venezuela. J. Essent. Oil Bear. Plants 2013, 16, 646–650. [Google Scholar] [CrossRef]
- da Silva Almeida, J.R.G.; de Souza, A.V.V.; de Oliveira, A.P.; dos Santos, U.S.; de Souza, M.D.; Bispo, L.P.; Turatti, I.C.C.; Lopes, N.P. Chemical composition of essential oils from the stem barks of Croton conduplicatus (Euphorbiaceae) native to the Caatinga biome. Afr. J. Pharm. Pharmacol. 2015, 9, 98–101. [Google Scholar] [CrossRef]
- Jaramillo-Colorado, B.; Duarte-Restrepo, E.; Jaimes, L. Bioactividad Del Aceite Esencial de Croton Trinitatis Millsp Colombiano. Bol. Latinoam. Caribe Plantas Med. Aromát. 2016, 15, 249–257. [Google Scholar]
- Vunda, S.L.L.; Sauter, I.P.; Cibulski, S.P.; Roehe, P.; Bordignon, S.A.L.; Rott, M.; Apel, M.A.; Von Poser, G.L. Chemical composition and amoebicidal activity of Croton pallidulus, Croton ericoides, and Croton isabelli(Euphorbiaceae) essential oils. Parasitol. Res. 2012, 111, 961–966. [Google Scholar] [CrossRef] [PubMed]
- Yagi, S.; Babiker, R.; Tzanova, T.; Schohn, H. Chemical composition, antiproliferative, antioxidant and antibacterial activities of essential oils from aromatic plants growing in Sudan. Asian Pac. J. Trop. Med. 2016, 9, 763–770. [Google Scholar] [CrossRef] [PubMed]
- Andrade, T.C.; De Lima, S.G.; Freitas, R.M.; Rocha, M.S.; Islam, M.; Da Silva, T.G.; Militão, G.C. Isolation, characterization and evaluation of antimicrobial and cytotoxic activity of estragole, obtained from the essential oil of croton zehntneri (euphorbiaceae). Anais Acad. Bras. Ciências 2015, 87, 173–182. [Google Scholar] [CrossRef]
- de Souza, A.V.V.; de Britto, D.; dos Santos, U.S.; Bispo, L.D.P.; Turatti, I.C.C.; Lopes, N.P.; de Oliveira, A.P.; Almeida, J.R.G.D.S. Influence of season, drying temperature and extraction time on the yield and chemical composition of ‘marmeleiro’ (Croton sonderianus) essential oil. J. Essent. Oil Res. 2017, 29, 76–84. [Google Scholar] [CrossRef]
- Dourado, R.C.; Silveira, E.R. Preliminary Investigation on the Volatile Constituents ofCroton sonderianusMuell. Arg.: Habitat, Plant Part and Harvest Time Variation. J. Essent. Oil Res 2005, 17, 36–40. [Google Scholar] [CrossRef]
- Lawal, O.A.; Ogunwande, I.A.; Osunsanmi, F.O.; Opoku, A.R.; Oyedeji, A.O. Croton gratissimus Leaf Essential Oil Composition, Antibacterial, Antiplatelet Aggregation, and Cytotoxic Activities. J. Herbs Spices Med. Plants 2016, 23, 77–87. [Google Scholar] [CrossRef]
- Hyldgaard, M.; Mygind, T.; Meyer, R.L. Essential Oils in Food Preservation: Mode of Action, Synergies, and Interactions with Food Matrix Components. Front. Microbiol. 2012, 3, 12. [Google Scholar] [CrossRef]
- Moo, C.-L.; Yang, S.-K.; Osman, M.-A.; Yuswan, M.H.; Loh, J.-Y.; Lim, W.-M.; Lim, S.-H.-E.; Lai, K.-S. Antibacterial Activity and Mode of Action of β-caryophyllene on Bacillus cereus. Pol. J. Microbiol. 2020, 69, 49–54. [Google Scholar] [CrossRef]
- Han, Y.; Chen, W.; Sun, Z. Antimicrobial activity and mechanism of limonene against Staphylococcus aureus. J. Food Saf. 2021, 41, e12918. [Google Scholar] [CrossRef]
- Pereira, F.G.; Marquete, R.; Domingos, L.T.; Rocha, M.E.; Ferreira-Pereira, A.; Mansur, E.; Moreira, D.L. Antifungal activities of the essential oil and its fractions rich in sesquiterpenes from leaves of Casearia sylvestris Sw. Anais Acad. Bras. Ciências 2017, 89, 2817–2824. [Google Scholar] [CrossRef] [PubMed][Green Version]
- Araújo, F.M.; Dantas, M.C.; e Silva, L.S.; Aona, L.; Tavares, I.F.; de Souza-Neta, L.C. Antibacterial activity and chemical composition of the essential oil of Croton heliotropiifolius Kunth from Amargosa, Bahia, Brazil. Ind. Crop. Prod. 2017, 105, 203–206. [Google Scholar] [CrossRef]
- Leite, T.R.; Da Silva, M.A.P.; Dos Santos, A.C.B.; Coutinho, H.D.M.; Duarte, A.E.; Da Costa, J.G.M. Antimicrobial, modulatory and chemical analysis of the oil of Croton limae. Pharm. Biol. 2017, 55, 2015–2019. [Google Scholar] [CrossRef]
- Nazzaro, F.; Fratianni, F.; DE Martino, L.; Coppola, R.; De Feo, V. Effect of Essential Oils on Pathogenic Bacteria. Pharmaceuticals 2013, 6, 1451–1474. [Google Scholar] [CrossRef]
- Burt, S. Essential oils: Their antibacterial properties and potential applications in foods—A review. Int. J. Food Microbiol. 2004, 94, 223–253. [Google Scholar] [CrossRef]
- Li, L.; Li, Z.-W.; Yin, Z.-Q.; Wei, Q.; Jia, R.-Y.; Zhou, L.-J.; Xu, J.; Song, X.; Zhou, Y.; Du, Y.-H.; et al. Antibacterial activity of leaf essential oil and its constituents from Cinnamomum longepaniculatum. Int. J. Clin. Exp. Med. 2014, 7, 1721–1727. [Google Scholar]
- Marinas, I.; Oprea, E.; Buleandra, M.; Badea, I.; Tihauan, B.; Marutescu, L.; Angheloiu, M.; Matei, E.; Chifiriuc, M. Chemical Composition, Antipathogenic and Cytotoxic Activity of the Essential Oil Extracted from Amorpha fruticosa Fruits. Molecules 2021, 26, 3146. [Google Scholar] [CrossRef]
- Dahham, S.S.; Tabana, Y.M.; Iqbal, M.A.; Ahamed, M.B.K.; Ezzat, M.O.; Majid, A.S.A.; Majid, A.M.S.A. The Anticancer, Antioxidant and Antimicrobial Properties of the Sesquiterpene β-Caryophyllene from the Essential Oil of Aquilaria crassna. Molecules 2015, 20, 11808–11829. [Google Scholar] [CrossRef]
- Sieniawska, E.; Sawicki, R.; Golus, J.; Swatko-Ossor, M.; Ginalska, G.; Skalicka-Wozniak, K. Nigella damascena L. Essential Oil—A Valuable Source of β-Elemene for Antimicrobial Testing. Molecules 2018, 23, 256. [Google Scholar] [CrossRef] [PubMed]
- Montanari, R.M.; Barbosa, L.C.A.; Demuner, A.J.; Silva, C.; Carvalho, L.S.; Andrade, N.J. Chemical composition and antibacterial activity of essential oils from verbenaceae species: Alternative sources of (E)-caryophyllene and germacrene-D. Química Nova 2011, 34, 1550–1555. [Google Scholar] [CrossRef]
- Marchese, A.; Arciola, C.R.; Barbieri, R.; Silva, A.S.; Nabavi, S.M.; Sokeng, A.J.T.; Izadi, M.; Jafari, N.J.; Suntar, I.; Daglia, M.; et al. Update on Monoterpenes as Antimicrobial Agents: A Particular Focus on p-Cymene. Materials 2017, 10, 947. [Google Scholar] [CrossRef] [PubMed]
- Dob, T.; Dahmane, D.; Benabdelkader, T.; Chelghoum, C. Composition and Antimicrobial Activity of the Essential Oil ofThymus fontanesii. Pharm. Biol. 2006, 44, 607–612. [Google Scholar] [CrossRef]
- Połeć, K.; Broniatowski, M.; Wydro, P.; Hąc-Wydro, K. The impact of β-myrcene – the main component of the hop essential oil – on the lipid films. J. Mol. Liq. 2020, 308, 113028. [Google Scholar] [CrossRef]
- Da Silva, A.C.R.; Lopes, P.M.; Azevedo, M.; Costa, D.C.M.; Alviano, C.S.; Alviano, D.S. Biological Activities of a-Pinene and β-Pinene Enantiomers. Molecules 2012, 17, 6305–6316. [Google Scholar] [CrossRef]
- Herman, A.; Tambor, K.; Herman, A.P. Linalool Affects the Antimicrobial Efficacy of Essential Oils. Curr. Microbiol. 2015, 72, 165–172. [Google Scholar] [CrossRef] [PubMed]
- Işcan, G.; Kırımer, N.; Demirci, F.; Demirci, B.; Noma, Y.; Başer, K.H.C. Biotransformation of (−)-(R)-α-Phellandrene: Antimicrobial Activity of Its Major Metabolite. Chem. Biodivers. 2012, 9, 1525–1532. [Google Scholar] [CrossRef]
- Rojas-Armas, J.P.; Arroyo-Acevedo, J.L.; Palomino-Pacheco, M.; Herrera-Calderón, O.; Sanchez, J.M.O.; Rojas-Armas, A.; Calva, J.; Castro-Luna, A.; Hilario-Vargas, J. The Essential Oil of Cymbopogon citratus Stapt and Carvacrol: An Approach of the Antitumor Effect on 7,12-Dimethylbenz-[α]-anthracene (DMBA)-Induced Breast Cancer in Female Rats. Molecules 2020, 25, 3284. [Google Scholar] [CrossRef]
- Rojas, R.; Bustamante, B.; Bauer, J.; Fernández, I.; Alban, J.; Lock, O. Antimicrobial activity of selected Peruvian medicinal plants. J. Ethnopharmacol. 2003, 88, 199–204. [Google Scholar] [CrossRef]
- CLSI. M07: Dilution AST for Aerobically Grown Bacteria. Available online: https://clsi.org/standards/products/microbiology/documents/m07/ (accessed on 15 October 2021).
- Liu, M.; Seidel, V.; Katerere, D.; Gray, A.I. Colorimetric broth microdilution method for the antifungal screening of plant extracts against yeasts. Methods 2007, 42, 325–329. [Google Scholar] [CrossRef] [PubMed]
- Holetz, F.B.; Pessini, G.L.; Sanches, N.R.; Cortez, D.A.G.; Nakamura, C.V.; Filho, B.P.D. Screening of some plants used in the Brazilian folk medicine for the treatment of infectious diseases. Memórias Inst. Oswaldo Cruz 2002, 97, 1027–1031. [Google Scholar] [CrossRef] [PubMed]

| N° | Chemicals | C. adipatus | C. thurifer | C. collinus | Chemical Group |
|---|---|---|---|---|---|
| % | % | % | |||
| 1 | Isobutyl isobutyrate | 0.2 | Carboxylic acid esters | ||
| 2 | α-Thujene | 12.69 | 1.7 | 0.17 | Monoterpene hydrocarbon |
| 3 | α-Pinene | 3.64 | 0.96 | 0.41 | Monoterpene hydrocarbon |
| 4 | Sabinene | 3.17 | 1.2 | 0.31 | Monoterpene hydrocarbon |
| 5 | β-Pinene | 1.55 | 0.38 | 0.36 | Monoterpene hydrocarbon |
| 6 | β-Myrcene | 18.34 | 6.79 | Monoterpene hydrocarbon | |
| 7 | Unknown (C10H16) | 22.38 | Monoterpene hydrocarbon | ||
| 8 | α-Phellandrene | 8.19 | 3.3 | 0.61 | Monoterpene hydrocarbon |
| 9 | Isoamyl isobutyrate | 0.53 | 0.99 | Fatty acid ester | |
| 10 | α-Terpinene | 0.56 | Monoterpene hydrocarbon | ||
| 11 | p-Cymene | 0.36 | 0.29 | Monoterpene hydrocarbon | |
| 12 | o-Cymene | 1.38 | Monoterpene hydrocarbon | ||
| 13 | D-Limonene | 10.94 | 1.94 | 8.73 | Monoterpene hydrocarbon |
| 14 | β- Thujene | 6.96 | Monoterpene hydrocarbon | ||
| 15 | β-Phellandrene | 4.94 | 1.44 | Monoterpene hydrocarbon | |
| 16 | Eucalyptol | 0.7 | 0.51 | Oxygenated monoterpenes | |
| 17 | γ-Terpinene | 0.88 | 2.1 | Monoterpene hydrocarbon | |
| 18 | cis-Ocimene | 0.43 | 0.35 | Monoterpene hydrocarbon | |
| 19 | τ−Τerpinene | 3.21 | Monoterpene hydrocarbon | ||
| 20 | β-Terpineol | 0.44 | Alcohol monoterpene | ||
| 21 | Terpinolene | 0.16 | 0.17 | Monoterpene hydrocarbon | |
| 22 | β-Linalool | 0.4 | Oxygenated monoterpenes | ||
| 23 | 1,6-Dimethylhepta-1,3,5-triene | 0.47 | Alkene | ||
| 24 | 4-Terpineol | 0.74 | Oxygenated monoterpenes | ||
| 25 | 2-Decanone | 0.17 | ketone | ||
| 26 | α-Terpineol | 0.12 | Oxygenated monoterpenes | ||
| 27 | 2-Undecanone | 2.16 | 0.72 | ketone | |
| 28 | 2-Dodecanone | 4.56 | ketone | ||
| 29 | 2-Carene | 0.56 | Monoterpene hydrocarbon | ||
| 30 | 1,5,5-Trimethyl-6-methylene-cyclohexene | 0.19 | Monoterpene hydrocarbon | ||
| 31 | Copaene | 0.44 | 0.28 | Monoterpene hydrocarbon | |
| 32 | Unknown I (C15H24) | 0.15 | 0.23 | Sesquiterpene hydrocarbon | |
| 33 | 1-Ethenyl-1-methyl-2,4-bis-(1-methylethenyl)-cyclohexane | 0.34 | Sesquiterpene hydrocarbon | ||
| 34 | Unknown II (C15H24) | 0.23 | Sesquiterpene hydrocarbon | ||
| 35 | β-Elemene | 6.47 | 11.87 | 6.7 | Sesquiterpene hydrocarbon |
| 36 | 2-Ethyl-1,3-dimethyl-Benzene | 0.24 | Benzene | ||
| 37 | Cyperene | 0.69 | 1.03 | Sesquiterpene hydrocarbon | |
| 38 | β-Caryophyllene | 0.28 | 1.95 | 44.7 | Sesquiterpene hydrocarbon |
| 39 | δ−Εlemene | 0.71 | Sesquiterpene hydrocarbon | ||
| 40 | Geranyl acetone | 0.16 | 0.59 | Monoterpene ketone | |
| 41 | Unknown III (C15H24) | 0.74 | Sesquiterpene hydrocarbon | ||
| 42 | Aromadendrene | 1.25 | 0.23 | Sesquiterpene hydrocarbon | |
| 43 | α-Caryophyllene | 0.3 | 3.73 | Sesquiterpene hydrocarbon | |
| 44 | Valencene | 0.53 | Sesquiterpene hydrocarbon | ||
| 45 | α-Elemene | 0.52 | Sesquiterpene hydrocarbon | ||
| 46 | Unknown IV (C15H24) | 1.43 | Sesquiterpene hydrocarbon | ||
| 47 | α-Curcumene | 0.39 | Sesquiterpene hydrocarbon | ||
| 48 | α-Muurolene | 0.45 | Sesquiterpene hydrocarbon | ||
| 49 | Unknown V (C15H24) | 0.59 | Sesquiterpene hydrocarbon | ||
| 50 | Germacrene D | 4.78 | 10.22 | 2.51 | Sesquiterpene hydrocarbon |
| 51 | α-Selinene | 0.39 | 0.21 | Sesquiterpene hydrocarbon | |
| 52 | Eremophilene | 0.67 | Sesquiterpene hydrocarbon | ||
| 53 | β-Cubebene | 0.22 | Sesquiterpene hydrocarbon | ||
| 54 | Bicyclogermacrene | 1.24 | 3.88 | Sesquiterpene hydrocarbon | |
| 55 | Geranil isobutyrate | 0.41 | Carboxylic ester monoterpene | ||
| 56 | Unknown I (C15H26O) | 3.73 | Sesquiterpene hydrocarbon | ||
| 57 | Unknown II (C15H26O) | 1.62 | Sesquiterpene hydrocarbon | ||
| 58 | δ-Cadinene | 0.48 | 1.26 | 1.96 | Sesquiterpene hydrocarbon |
| 59 | α-Muurolene | 0.51 | Sesquiterpene hydrocarbon | ||
| 60 | Unknown VII (C15H24) | 0.31 | 0.76 | Sesquiterpene hydrocarbon | |
| 61 | Elemol | 1.61 | Oxygenated sesquiterpene | ||
| 62 | Unknown VIII (C15H24) | 0.69 | Sesquiterpene hydrocarbon | ||
| 63 | (-)-Spatulenol | 0.58 | Oxygenated sesquiterpene | ||
| 64 | Unknown (C15H24O) | 0.89 | n.d. | ||
| 65 | Unknown III (C15H26O) | 0.51 | 0.64 | n.d. | |
| 66 | Unknown (C15H22O) | 0.31 | n.d. | ||
| 67 | β-Maaliene | 0.11 | Sesquiterpene hydrocarbon | ||
| 68 | Unknown (C9H14O) | 1.15 | n.d. | ||
| 69 | τ-Muurolene | 0.15 | Sesquiterpene hydrocarbon | ||
| 70 | Unknown IV (C15H26O) | 0.1 | 21.8 | n.d. | |
| 71 | τ-Muurolol | 0.16 | 0.34 | Oxygenated sesquiterpene | |
| 72 | α-Cadinol | 0.73 | Oxygenated sesquiterpene | ||
| 73 | Unknown V (C15H26O) | 0.38 | 0.28 | n.d. | |
| 74 | Heptadecane | 0.12 | 0.26 | 0.49 | Alkane |
| Total of identified compounds (%) | 100.00 | 100.00 | 100.00 | ||
| Microorganism | Zone of Inhibition (mm) | ||||||||||
|---|---|---|---|---|---|---|---|---|---|---|---|
| Essential Oil | Positive Control | ||||||||||
| Croton adipatus | Croton thurifer | Croton collinus | CIP [0.05 mg/mL] | KET [0.2 mg/mL] | |||||||
| 10% | 50% | 95% | 10% | 50% | 95% | 10% | 50% | 95% | |||
| Sa | 13.13 ± 0.44 * | 20 ± 0 * | 14.2 ± 0.7 * | 11.47 ± 0.5 * | 12 ± 0 * | 14.07 ± 0.41 * | 10.53 ± 0.55 * | 11.03 ± 0.52 * | 12 ± 0 * | 39 ± 0 | n.d. |
| Bs | 13.1 ± 1.32 * | 17.13 ± 0.34 * | 25 ± 0 * | 11.5 ± 0 * | 12.53 ± 0.46 * | 12.17 ± 1.25 * | 12.6 ± 0.8 * | 14.53 ± 0.4 * | 15 ± 0 * | 52.3 ± 1.1 | n.d. |
| Ec | 14.03 ± 0.41 | 16 ± 0 | 20.03 ± 0.29 * | 10 ± 0 * | 12.03 ± 0.48 * | 11.53 ± 0.5 * | 11 ± 0 * | 11.57 ± 0.5 * | 10.6 ± 1.63 * | 15 ± 0 | n.d. |
| Pa | 11.27 ± 1.02 * | 11.53 ± 0.5 * | 13.57 ± 0.85 * | 10 ± 0 * | 12.5 ± 0 * | 11 ± 0 * | 11.63 ± 1.31 * | 12.7 ± 0.79 * | 11.03 ± 0.52 * | 34 ± 0 | n.d. |
| Ca | 19.67 ± 1.47 # | 12.5 ± 0 # | 11 ± 0# | 15.03 ± 0.38# | 11 ± 0 # | 10 ± 0 # | 15 ± 0 # | 10.53 ± 0.55 # | 10 ± 0 # | n.d. | 35 ± 0 |
| Microorganism | Minimum Inhibitory Concentration (MIC) | ||||
|---|---|---|---|---|---|
| Essential Oil (µg/mL) | Positive Control (µg/mL) | ||||
| Croton adipatus | Croton thurifer | Croton collinus | Ciprofloxacin | Ketoconazole | |
| Sa | >1000 | 296.1 ± 0 | >1000 | 0.5 ± 0 | n.d. |
| Bs | 286.4 ± 0 | 148 ± 0 | 72 ± 0 | 0.13 ± 0 | n.d. |
| Ec | >1000 | >1000 | >1000 | 4 ± 0 | n.d. |
| Pa | >1000 | >1000 | >1000 | 32 ± 0 | n.d. |
| Ca | 572.8 ± 0 | >1000 | 576.2 ± 0 | n.d. | 0.03 ± 0 |
Publisher’s Note: MDPI stays neutral with regard to jurisdictional claims in published maps and institutional affiliations. |
© 2021 by the authors. Licensee MDPI, Basel, Switzerland. This article is an open access article distributed under the terms and conditions of the Creative Commons Attribution (CC BY) license (https://creativecommons.org/licenses/by/4.0/).
Share and Cite
Cucho-Medrano, J.L.L.; Mendoza-Beingolea, S.W.; Fuertes-Ruitón, C.M.; Salazar-Salvatierra, M.E.; Herrera-Calderon, O. Chemical Profile of the Volatile Constituents and Antimicrobial Activity of the Essential Oils from Croton adipatus, Croton thurifer, and Croton collinus. Antibiotics 2021, 10, 1387. https://doi.org/10.3390/antibiotics10111387
Cucho-Medrano JLL, Mendoza-Beingolea SW, Fuertes-Ruitón CM, Salazar-Salvatierra ME, Herrera-Calderon O. Chemical Profile of the Volatile Constituents and Antimicrobial Activity of the Essential Oils from Croton adipatus, Croton thurifer, and Croton collinus. Antibiotics. 2021; 10(11):1387. https://doi.org/10.3390/antibiotics10111387
Chicago/Turabian StyleCucho-Medrano, Juana Liz Leslie, Sammy Wesley Mendoza-Beingolea, César Máximo Fuertes-Ruitón, María Elena Salazar-Salvatierra, and Oscar Herrera-Calderon. 2021. "Chemical Profile of the Volatile Constituents and Antimicrobial Activity of the Essential Oils from Croton adipatus, Croton thurifer, and Croton collinus" Antibiotics 10, no. 11: 1387. https://doi.org/10.3390/antibiotics10111387
APA StyleCucho-Medrano, J. L. L., Mendoza-Beingolea, S. W., Fuertes-Ruitón, C. M., Salazar-Salvatierra, M. E., & Herrera-Calderon, O. (2021). Chemical Profile of the Volatile Constituents and Antimicrobial Activity of the Essential Oils from Croton adipatus, Croton thurifer, and Croton collinus. Antibiotics, 10(11), 1387. https://doi.org/10.3390/antibiotics10111387

